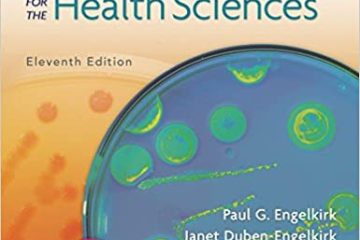

kijiji_ads
Member since 2 years
Toronto, Ontario, Canada
User Ads
4506




Various Types of Sports Balls
CAD$5
Quick preview
Add to compare
Add to favorites
16 Views




DECORATIVE DOOR SIDE LIGHTS WITH CANING
CAD$250
Quick preview
Add to compare
Add to favorites
18 Views




East Indian Stamp Collection + Lots More 4794-4800
CAD$65
Quick preview
Add to compare
Add to favorites
20 Views


CB2 Coffee Table
CAD$300
Quick preview
Add to compare
Add to favorites
15 Views




FURNISHED 2BDRM 2Bath Bay St Condo Sleeps6 at Sick Kids Hospital
CAD$6,998
Quick preview
Add to compare
Add to favorites
17 Views




Do You Know Toronto Tried to Host The 2008 Olympics ? 2475
Quick preview
Add to compare
Add to favorites
20 Views



baby car seat
CAD$50
Quick preview
Add to compare
Add to favorites
21 Views


Canadian Controllership Guide Volume I Planning 9780779867080
Quick preview
Add to compare
Add to favorites
16 Views




Stamps of Thailand + More For Sale 4776-78
CAD$25
Quick preview
Add to compare
Add to favorites
19 Views

Burton’s Microbiology for the Health Sciences 11th 9781496380463
Quick preview
Add to compare
Add to favorites
21 Views




Disney Mickey Mouse & Freinds Charpente/Disney Picture Frame
CAD$25
Quick preview
Add to compare
Add to favorites
16 Views




80% TRE AD LT225/75R16 10PR E MICHELIN AGILIS CROSSCLIMIT
CAD$75
Quick preview
Add to compare
Add to favorites
15 Views
Useful Links
Categories
Newest Listings
© 2024 QuickBestSales. All rights reserved.



